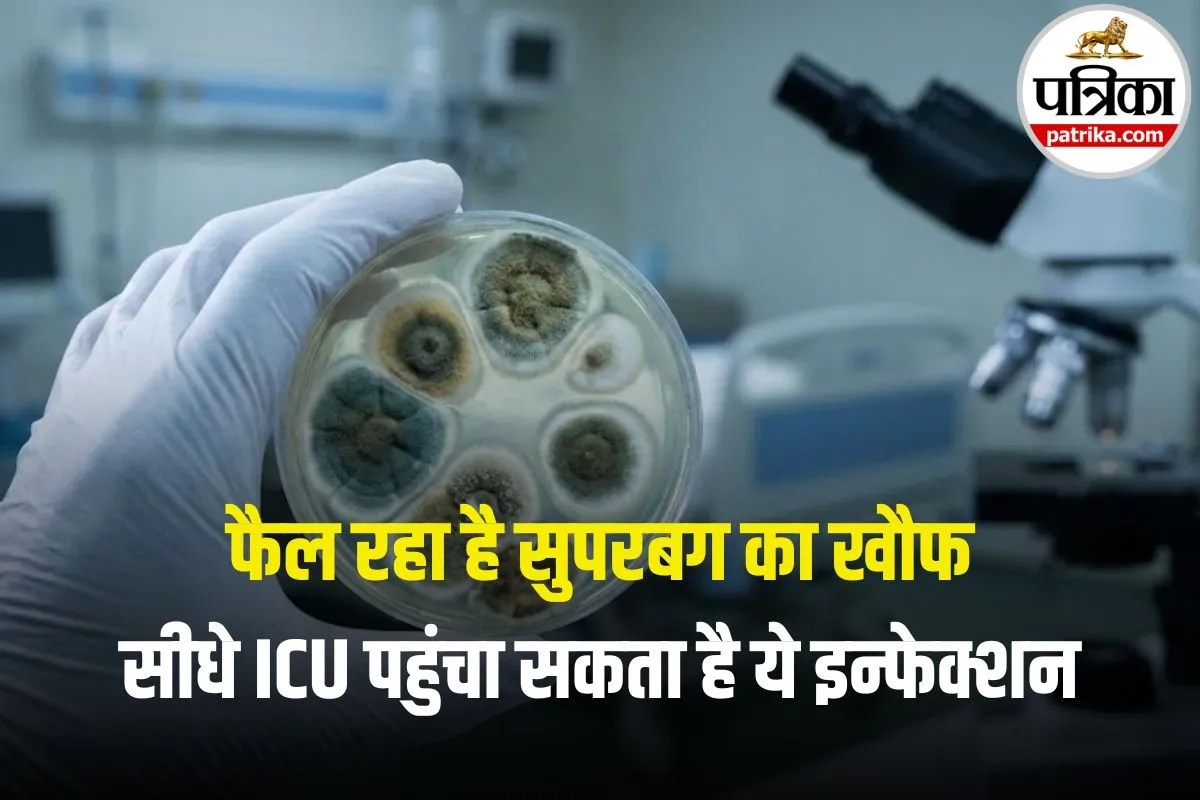

Candida Auris Superbug (Photo- gemini ai)
Candida Auris Superbug: अमेरिका में एक गंभीर हेल्थ अलर्ट जारी किया गया है। वजह है Candida auris नाम का एक खतरनाक फंगस (खमीर), जो तेजी से अलग-अलग राज्यों में फैल रहा है। यह कोई आम इंफेक्शन नहीं, बल्कि ऐसा सुपरबग है जिस पर कई दवाएं असर नहीं करतीं। खासतौर पर जिन लोगों की इम्युनिटी कमजोर होती है, उनके लिए यह जानलेवा साबित हो सकता है।
Candida auris एक तरह का फंगस है जो शरीर के अंदर जाकर गंभीर इंफेक्शन कर सकता है। इसे पहली बार साल 2009 में जापान में एक मरीज के कान में पाया गया था। इसके बाद यह कई देशों में फैल गया। भारत में भी इसे 2014 में एक बड़े पब्लिक हेल्थ खतरे के रूप में पहचाना गया। CDC (अमेरिका की हेल्थ एजेंसी) के मुताबिक, अब तक 28 राज्यों में करीब 7,000 से ज्यादा लोग इससे संक्रमित हो चुके हैं। यह फंगस खासकर अस्पतालों और नर्सिंग होम्स में तेजी से फैलता है।
इस फंगस की सबसे बड़ी परेशानी यह है कि यह साफ-सफाई और डिसइंफेक्टेंट से भी आसानी से खत्म नहीं होता है। महीनों तक सतहों और त्वचा पर जिंदा रह सकता है। मेडिकल उपकरणों और इंसान से इंसान में फैल सकता है। इसके कुछ स्ट्रेन ऐसे हैं जिन पर कोई एंटी-फंगल दवा काम नहीं करती है। यानी अगर इंफेक्शन बहुत ज्यादा दवा-रेजिस्टेंट हो गया, तो इलाज बेहद मुश्किल हो जाता है।
CDC के अनुसार यह फंगस अमेरिका के ओरेगॉन, कैलिफोर्निया, नेवादा, मोंटाना, व्योमिंग, कोलोराडो, यूटा, एरिज़ोना, कंसास, टेक्सास, आयोवा, लुइसियाना, विस्कॉन्सिन, इलिनोइस, मिशिगन, इंडियाना, ओहियो, केंटकी, टेनेसी, मिसिसिपी, पेंसिल्वेनिया, वेस्ट वर्जीनिया, मैरीलैंड, डेलावेयर, वर्जीनिया, जॉर्जिया, नॉर्थ कैरोलिना और अलबामा में फैल रहा है।
Candida auris के लक्षण इस बात पर निर्भर करते हैं कि यह शरीर के किस हिस्से में इंफेक्शन कर रहा है। हाल की एक स्टडी के मुताबिक, कई मरीजों को ICU में भर्ती करना पड़ा और कुछ को वेंटिलेटर की जरूरत भी पड़ी।
अगर किसी को ये लक्षण लंबे समय तक बने रहें, खासकर अस्पताल में भर्ती मरीजों या बुजुर्गों में, तो तुरंत डॉक्टर से संपर्क करें। समय पर पहचान और सावधानी ही इस खतरनाक फंगस से बचने का सबसे अच्छा तरीका है।
Published on:
02 Jan 2026 08:41 am
बड़ी खबरें
View Allस्वास्थ्य
ट्रेंडिंग
लाइफस्टाइल
